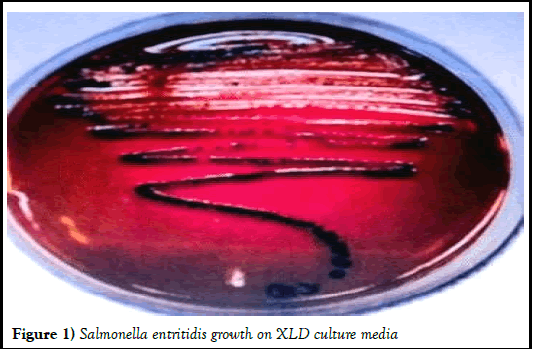
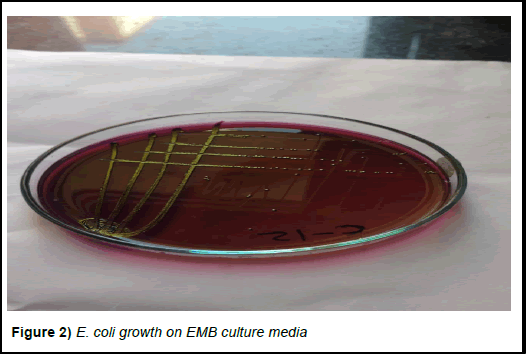

Clinico-haemato-biochemical and therapeutic studies on enteritis in goats
2 Department of Veterinary Medicine, LUVAS, Hisar, Rajasthan, India
3 Department of Livestock Production Management, CVAS, RAJUVAS, Bikaner, India
Received: 27-Oct-2023, Manuscript No. PULJVRP-23-6833; Editor assigned: 30-Oct-2023, Pre QC No. PULJVRP-23-6833 (PQ); Reviewed: 13-Nov-2023 QC No. PULJVRP-23-6833; Revised: 17-Jan-2025, Manuscript No. PULJVRP-23-6833 (R); Published: 24-Jan-2025
Citation: Dhaka MK, Yadav R, Choudhary S, et al. Clinico-haemato-biochemical and therapeutic studies on enteritis in goats. J Vet Res Med. 2025;7(1): 1-4.
This open-access article is distributed under the terms of the Creative Commons Attribution Non-Commercial License (CC BY-NC) (http://creativecommons.org/licenses/by-nc/4.0/), which permits reuse, distribution and reproduction of the article, provided that the original work is properly cited and the reuse is restricted to noncommercial purposes. For commercial reuse, contact reprints@pulsus.com
Abstract
The study was conducted in sixteen goats of 6 months to 3 years of age suffering from enteritis, presented at teaching veterinary clinical complex, Rajuvas, Bikaner (Rajasthan). These goats were presented with the typical clinical signs and symptoms of diarrheic faeces, in appetence to anorexia, dull and depressed, and mild to moderate dehydration since the last 2-3 days. Blood and serum samples of all these enteritis affected goats were collected by standard procedures on the day first before initiation of the treatment. For therapeutic management, these goats were randomly divided in two groups (groups–I and II) containing 8 animals in each group. The animals of group–I were treated with ofloxacin at 5 mg/kg body weight by intramuscular rote daily and group-II were administered with a combination of sulphadiazine (400 mg/ml)+trimethoprim (80 mg/ml) at 1 ml/10 kg body weight intramuscularly daily for 3 days. In both groups supportive treatment in the form of NSAIDs (meloxicam), multivitamins (vitamin B1, B6 and B12) and fluid therapy (normal saline solution and Ringer’s lactate) was given in standard recommended doses for 3 days. After 3 days of regular treatment, it was found that the treatment regime provided to the goats of both group–I and group-II were recovered based on the remission of clinical signs and symptoms but group-I was considerably more effective.
Keywords
Clinical; Biochemical; Therapeutic; Goats
Introduction
Goat is the second most important livestock in India, which plays an important role in rural economy and is known as poor man’s cow [1]. Identifying the etiological agents is not always possible, and field and laboratory studies have shown that there is no single agent in the etiology of neonatal enteritis. Entero-pathogenic bacteria, viruses, and protozoa, as well as the immune system of animal and environmental factors, all play roles in the disease [2].
Diarrhoea is documented as a frequent cause of neonatal mortality among animals including goats throughout the world. Enterotoxigenic Escherichia coli (ETEC) and Cryptosporidium parvum are considered among the most prevalent causative agent of enteritis in goats. Bacterial enteritis is the most important cause of diarrhoea in lambs and goat kids. It is caused by pathogenic serotypes of Escherichia coli [3]. Animals suffering from white scour have severe colitis characterized by abdominal pain, pasty faeces, sever enteritis that may culminates into death due to severe dehydration [4]. Salmonella enteritidis produces enterotoxins which are invasive to cause inflammatory changes within the intestine leading to diarrhoea, Bacterial enteritis remains the most common clinical problem in the goats. Despite improvements in managemental practices and prevention and treatment strategies, enteritis is still the most common and costly disease affecting small ruminants.
Gastrointestinal (GI) parasitism causing major threats such as production losses in small animal industry and mortality in severe cases has been reported [5]. Helminth infection of the gastrointestinal tract is one of the major problems in goats which are characterized clinically by enteritis, anemia, emaciation, dehydration, and death. These changes are responsible to affect the growth, body weight, yield, and reproductive performance of the animal leading to economic loss of the farmer [6].
Serum biochemistry and haematological analysis have been found to be an important and reliable indicator for assessing an animal’s health status and might give an assessment of the degree of damage to the host tissue as well as the severity of infection resulting in anemia, hypoproteinemia, and lower blood glucose [7-10].
Materials and Methods
This study was conducted at teaching veterinary clinical complex, Rajuvas, Bikaner (Rajasthan) in sixteen goats of 6 months to 3 years of age suffering from enteritis, presenting with clinical signs and symptoms of diarrheic faeces, in appetence to anorexia, dull and depressed and mild to moderate dehydration since last 2-3 days [11].
Collection of samples
For haematobiological examination, blood samples from these 16 goats were collected on day 0 and then post-treatment by jugular vein puncture in EDTA sterile and non-EDTA sterile vacuutainers. The serum was harvested in small pyrex tubes and was stored in the deep freeze at -20â?? until analysis [12].
For haematological examination, blood samples were analysed for haemoglobin, packed cell volume, total erythrocyte count, total leukocyte count, and differential leukocyte count as described by Jain.
Biochemical analysis of serum samples was made to ascertain liver function by estimating serum total protein, creatinine, and serum glucose. All the parameter was estimated by using IDEXX vet test chemistry analyzer [13].
Faecal samples were collected prior to the start of the treatment with the help of sterile cotton swabs in screw-capped plastic tubes and in sterile vials. Collected faecal samples were kept in a cool transport box and brought to the postgraduate laboratory, CVAS, Bikaner, for further examination [14]. Faecal examination for endoparasites by using flotation and sedimentation procedure and observed under microscope. The collected samples were cultured on EMB (Eosin methylene blue) and XLD (Xylose Lysin Deoxycholate) agar plate and incubate at 37â?? for 24 hrs. Distinct colony was identified as E. coli and Salmonella.
Treatment
For therapeutic management, these goats were randomly divided in two groups (groups–I and II) containing 8 animals in each group. The animals of group–I were treated with ofloxacin at 5 mg/kg body weight by intramuscular rote daily and group-II were administered with a combination of sulphadiazine (400 mg/ml)+trimethoprim (80 mg/ml) at 1 ml/10 kg body weight intramuscularly daily for 3 days [15]. In both groups antidiarrhal herbal preparation (Diaroak) 0.5 gm per 10 kg Bwt, orally BD and with the same supportive treatment in the form of NSAIDs (meloxicam), multivitamins (vitamin B1, B6 and B12), and fluid therapy (normal saline solution and Ringer’s lactate) was given in standard recommended doses for 3 days [16]
Results and Discussion
In the present study, there were 16 goats selected which have signs of severe enteritis and 8 healthy goats were selected to use as control (Figures 1 and 2). Faecal samples collected from both diarrhoeic groups (group-1) for parasitic and bacteriological examination were found to be negative for endoparasites and positive for either Salmonella enteritidis or Escherichia coli (E. coli) [17].
Figure 1) Salmonella entritidis growth on XLD culture media.
In this study, a significant decrease in total erythrocyte count, hemoglobin, and PCV (group-1, 9.57 ± 1.19, 6.90 ± 0.40 and 20.34 ± 0.79 or group-II 9.83 ± 0.64, 6.73 ± 0.37 and 19.90 ± 1.02 respectively) on 0 day compared to healthy animals (group-III 12.29 ± 0.69, 10.60 ± 0.40 and 31.47 ± 1.51 respectively). In comparison, a significant increase in TEC, Hb, and PCV (group-1 , 12.01 ± 0.64, 9.75 ± 0.41 and 28.82 ± 0.79 or group-II 11.46 ± 0.54, 9.58 ± 0.43 and 28.38 ± 1.24 respectively) was found at post treatment compared to the start of treatment within the same group (Table 1). Reduction in haematocrit values due to haemorrhage in intestinal mucosa results in anemia and decreased PCV value also. On post treatment these values were shifted significantly to the normal range. Phad recorded the reduction in haematocrit values in chicks orally infected with E. coli [18]. The reduction in PCV, Hb, and total erythrocyte may be found.
Figure 2) E. coli growth on EMB culture media
| Parameters | Group-III (Healthy animal) | Group-I | Group-II | ||
| Pre | Post | Pre | post | ||
| Erythrogram | |||||
| RBCs (106/mm3) | 12.29A ± 0.69 | 9.57aB ± 1.19 | 12.01b ± 0.64 | 9.83aB ±0.64 | 11.46b ±0.54 |
| Hb (gm per cent) | 10.60A ± 0.40 | 6.90aB ±0.40 | 9.75b ±0.41 | 6.73aB ±0.37 | 9.58b ± 0.43 |
| PCV (per cent) | 31.47A ± 1.51 | 20.34aB ±0.79 | 28.82b ±0.79 | 19.90aB ± 1.02 | 28.38b ± 1.24 |
| TLC (103/mm3) | 11.95 ± 0.67 | 11.70 ± 1.22 | 11.81 ± 0.70 | 12.70 ± 0.88 | 12.68 ± 0.62 |
| Differential leucocytic count (per cent age) | |||||
| Lymphocyte | 48.63 ± 1.02 | 47.13 ± 3.65 | 49.63 ± 1.60 | 46.88 ± 3.15 | 47.75 ± 0.87 |
| Neutrophils | 48.75 ± 0.92 | 47.13 ± 4.00 | 47.75 ± 1.84 | 46.25 ± 3.05 | 48.38 ± 1.19 |
| Eosinophils | 0.13 ± 0.14 | 0.38 ± 0.30 | 0.13 ± 0.14 | 0.38 ± 0.30 | 0 |
| Monocytes | 2.75A ± 0.61 | 5.25aB ± 0.68 | 3.38b ± 0.49 | 6.50a ± 0.69 | 3.88b ± 0.74 |
| Note: 1) Mean ± SE bearing different superscripts (A, B) between treated and control groups differed significantly (p<0.05). 2) Mean ± SE bearing different superscripts (a, b) within the treated groups differed significantly (p<0.05) | |||||
Table 1: Mean ± SE values of hematology at pre-and post-treatment in treated groups
In biochemical parameters were found significantly low in total serum protein (group-I 4.87 ± 0.27 and group-II 4.69 ± 0.32) and high in creatinine (group-I 1.49 ± 0.16 and group-II 1.40 ± 0.18) on day 0 in group comparison to control group animals (group-III 5.22 ± 0.14 and 0.90 ± 0.07 respectively). Whereas, a significant increase in total serum protein (group-â? 5.47 ± 0.17 and group-II 5.52 ± 0.20) and a decrease in creatinine (group-I 1.10 ± 0.09 and group-II 0.91 ± 0.07) at post treatment compared to the same group at the start of treatment (Table 2). Decrease in serum protein loss of protein through feces and decreased absorption in the body through the intestinal wall due to inflammation or eruption of mucosa and increased serum concentration of creatinine indicate severe dehydration during enteritis. Post treatment the body is trying to adjust for these values in the normal range. Whereas, there was no significance difference found in TLC, DLC, and serum glucose levels in diseased goats.
Phad and Deshmukh observed a reduction in total serum protein and glucose levels in E. coli infected birds. Increase levels of creatinine in enteritis affected animals also have been recorded.
| Parameters | Group-III (Healthy animal) | Group-I | Group-II | ||
|---|---|---|---|---|---|
| Pre | Post | Pre | post | ||
| Total protein (g/dl) | 5.22A ± 0.14 | 4.87aB ± 0.27 | 5.47b ± 0.17 | 4.69aB ± 0.32 | 5.52b ± 0.20 |
| Creatinine (mg/dl) | 0.90A ± 0.07 | 1.49aB ± 0.16 | 1.10b ± 0.09 | 1.40aB ± 0.18 | 0.91b ± 0.07 |
| Glucose (mg/dl) | 61.67 ± 1.13 | 60.79 ± 1.99 | 62.43 ± 1.32 | 61.26 ± 1.07 | 61.91 ± 1.10 |
| Note: Mean ± SE bearing different superscripts (A, B) between treated and control groups differed significantly (p<0.05) | |||||
Table 2: Mean ± SE values of biochemical at pre-and post-treatment in treated groups
Extreme cases treated with herbal formulation combination with ofloxacin found negative of E. coli and showed immediate recovery from the diarrhoea after treatment. The antimicrobial agents ciprofloxacin appears to be a logical alternative to trimethoprim-sulfamethoxazole in the initial treatment of acute traveller’s diarrhoea caused by enterotoxigenic Escherichia coli, invasive enteropathogens, and unknown pathogens. Fluoroquinolones are highly active against most gram-negative pathogens, as well as Staphylococcus aureus and coagulase-negative staphylococci.
Conclusion
After 3 days of regular treatment, it was found that the treatment regime provided to the goats of both group I and group II were recovered but group I was more effective based on the hematobiochemical and early remission of clinical signs and symptoms.
Acknowledgement
The authors wish in their deep sense of gratitude and all praise to the Almighty and sincerely thanks to HOD, Clinical Veterinary Medicine and Dean, CVAS Bikaner who helped by providing support in completing this work.
References
- Adefarakan TA, Oluduro AO, David OM, et al. Prevalence of antibiotic resistance and molecular characterization of Escherichia coli from faeces of apparently healthy rams and goats in Ile-Ife, Southwest, Nigeria. Ife J Sci. 2014;16(3):447-60.
- Amulya G, Sudharani R, Shareef MI, et al. Haemato-Biochemical changes in sheep suffering from gastrointestinal parasitism. Indian J Vet Scie Biotechnol. 2014;10(2):20-2.
- Bhat MS, Sudhan NA, Mir AQ. Haemato-biochemical studies in sheep infected with natural gastrointestinal nematodiasis. 2004:76-8.
- Bhat MA, Nishikawa Y, Wani SA. Prevalence and virulence gene profiles of Shiga toxin-producing Escherichia coli and enteropathogenic Escherichia coli from diarrhoeic and healthy lambs in India. Small Ruminant Res. 2008;75(1):65-70.
- Constable PD, Hinchcliff KW, Done SH, et al. A textbook of the diseases of cattle, horses, sheep, pigs, and goats. Vet Med. 2017;11:412-8.
- Das S, Nath R, Balamurugan V, et al. Haematobiochemical analysis of goats naturally infected with peste des petits ruminants. Int J Res Emer Scie Technol. 2015;2(9):19-24.
- Deshmukh VV. Studies on efficacy of Levofloxacin in experimental Colibacillosis in Broilers. Doctoral dissertation, MAFSU, Nagpur. 2006.
- Teleb DF. Effect of Fascioliasis on hematological, serum biochemical and histopathological changes in sheep. Egyptian J Sheep Goats Sci. 2007;2(2):1-2.
- Ericsson CD, Johnson PC, Dupont HL, et al. Ciprofloxacin or trimethoprim-sulfamethoxazole as initial therapy for travelers' diarrhea: A placebo-controlled, randomized trial. Ann Intern Med. 1987;106(2):216-20.
[Crossref] [Google Scholar] [PubMed]
- Fitton A. The quinolones: An overview of their pharmacology. Clin Pharmacokinet. 1992;22(Suppl 1):1-1.
[Crossref] [Google Scholar] [PubMed]
- NC J. Schalm’s veterinary haematology. 4th Edition. Lea and Fabiger. 1986.
- Hassanein KM, Sayed MM, Hassan AM. Pathological and biochemical studies on enterotoxemia in sheep. Comp Clin Pathol. 2017;26:513-8.
- Meshram D, Ravikanth K, Maini S, et al. Treatment of clinical cases of bacterial enteritis in goat with new polyherbal antidiarrhoeal formulation. Vet World. 2009;2(4):143.
- Otesile EB, Fagbemi BO, Adeyemo O. The effect of Trypanosoma brucei infection on serum biochemical parameters in boars on different planes of dietry energy. Vet Parasitol. 1991;40(3-4):207-16.
[Crossref] [Google Scholar] [PubMed]
- Phad VN. Studies on Experimental Colibacillosis in Broilers. Doctoral dissertation, MAFSU, Nagpur. 2005.
- Scott PR, Gessert ME. Watery mouth disease in lambs: Biochemical parameters before and after treatment. Vet Rec. 1996; 139(5):117-8.
[Crossref] [Google Scholar] [PubMed]
- Sharma P, Sharma D, Dogra PK, et al. Comparative efficacy of fenbendazole and oxyclozanide-tetramisole combination against gastrointestinal nematodes in naturally infected Gaddi goats. Vet Res Int. 2014;2(1):15-7.
- Tariq KA, Chishti MZ, Ahmad F. Gastro-intestinal nematode infections in goats relative to season, host sex and age from the Kashmir valley, India. J Helminthol. 2010;84(1):93-7.
[Crossref] [Google Scholar] [PubMed]